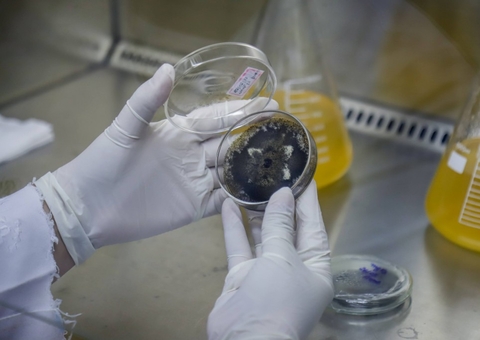
Estudo investiga uso de mandioca no tratamento de câncer de pele

Manaus/AM - O Amazonas diagnosticou 88 novos casos de Covid-19, totalizando 584.145 casos da doença no estado. Segundo consta no boletim, foi confirmado 1 óbito pela Covid-19, ocorrido no domingo (26), elevando para 14.178 o total de mortes.
Municípios
Dos 584.145 casos confirmados no Amazonas até esta segunda-feira (27/06), 291.980 são de Manaus (49,94%) e 292.165 do interior do estado (50,06%).
A capital, Manaus, tem 75 novos casos confirmados. No interior, os 3 municípios que têm casos novos são: Lábrea (5), Coari (4) e Iranduba (4).
Óbitos
Entre as vítimas em Manaus, há o registro de 9.705 óbitos confirmados em decorrência do novo coronavírus. No interior, são 61 municípios com óbitos confirmados até o momento, totalizando 4.473.Há um novo óbito em Manaus.

Aviso